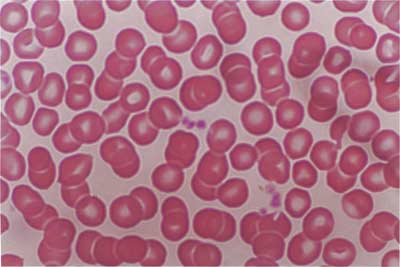

网络预约,优先就诊。
提交预约后,5-10分钟内客服将会与您联系,确认预约详情,请耐心等候。
北京市西城区德外大街200号(德胜门城楼东北角)

原发性骨髓纤维化症诊断依据是什么?任何一种疾病都是有自己的症状的,很多时候我们都是根据它的症状也诊断病情的,随着原发性骨髓纤维化症的人逐渐在增多,人们开始关注此种疾病,那原发性骨髓纤维化症诊断依据是什么?
原发性骨髓纤维化症诊断依据是什么?
1.脾脏明显肿大。
2.外周血象出现幼稚粒细胞和/或有核红细胞,有数量不一的泪滴状红细胞,病程中可有红细胞、白细胞及血小板的增多或减少。
3.骨髓穿刺多次“干抽”或呈“增生低下”。
4.脾、肝、淋巴结病理检查示有造血灶。
5.骨髓活检病理切片显示纤维组织明显增生。
以上就是专家对原发性骨髓纤维化症诊断依据是什么的介绍,上述第5项为必备条件,加其他任何两项,并能排除继发性骨髓纤维化者,可诊断本病。